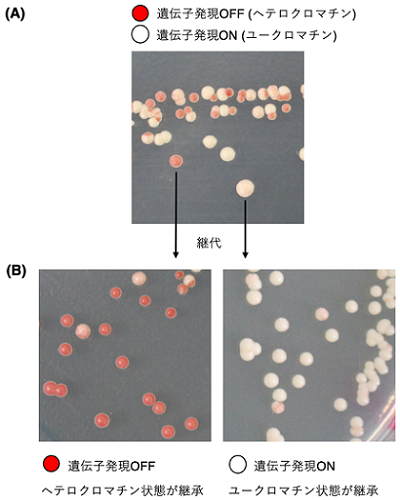

公開日 2024年11月14日
島根大学医学部生命科学講座 川上慶助教(研究当時:関西学院大学生命環境学部 助教)は、関西学院大学生命環境学部 田中克典教授らと共同で、遺伝子発現を抑制する染色体構造が、親細胞から娘細胞へと安定に受け継がれるメカニズムを解明しました。研究成果はWiley社が刊行する国際誌Genes to Cellsに、2024年10月29日(日本時間)にオンライン掲載されました。
【本研究成果のポイント】
- 分裂酵母の細胞の中で、遺伝子の発現が抑制される染色体構造(ヘテロクロマチン)が構築された後、その構造が親細胞から娘細胞へと受け継がれる様子をモニターできる実験系を作製。
- 親細胞のヘテロクロマチンを安定に維持し、娘細胞に継承するために必要な遺伝子を57個同定。
- そのうちの一つ、DNA複製チェックポイント因子であるMrc1が、ヒストン脱アセチル化酵素Clr3を呼び込み、ヘテロクロマチン構造の安定な維持・継承を促進することを解明。
【研究の内容と成果】
細胞記憶とその継承のメカニズムについて、本研究では、単細胞生物である分裂酵母をモデル系に用いて研究を行いました。酵母は細胞分裂を繰り返して自己を増やします。これらの増殖した酵母は互いに同じゲノムDNAを持っています(これらの細胞は互いにクローンと呼ばれます)。分裂酵母でよく使用されるレポーター遺伝子にade6遺伝子があります。ade6の発現がOFFの細胞は、アデニンの欠乏した培地上で赤いコロニーを形成します。一方、ade6の発現がONの細胞は白いコロニーを形成します。
今回、我々は、分裂酵母の染色体末端付近にあるサブテロメアと呼ばれる領域にade6遺伝子を挿入し、その遺伝子発現の状態をコロニーの色(赤か白)で解析しました。すると、興味深いことに、サブテロメアに挿入したade6遺伝子の発現は、ONになったりOFFになったりと、クローン間に個性があることが分かりました(図1A)。ade6遺伝子の周辺がヘテロクロマチン状態になったり、ユークロマチン状態になったりと、エピジェネティックな状態に多様性があると考えられます。面白いことに、赤と白のコロニーをさらに継代してみると、赤いコロニーからは赤いコロニーが、白いコロニーからは白いコロニーが生じることが分かりました(図1B)。つまり、ade6遺伝子の発現の状態(ON か OFF)は細胞に記憶され、細胞分裂を経ても娘細胞に継承されたのです。この実験系を用いることで、細胞記憶の状態を赤、白のコロニーで簡単に判別できるようになりました。
図1:細胞記憶の状態をコロニーの色でモニターできる実験系の作製 Kawakami et al., 2024 Genes to Cells Fig.1より改変の後、転載 (1)。
(A)サブテロメアにade6遺伝子を挿入した分裂酵母のコロニー。細胞(コロニー)ごとに、ade6遺伝子の発現状態に多様性がある(赤いコロニーはade6遺伝子がOFFのヘテロクロマチン状態、白いコロニーはade6遺伝子がONのユークロマチン状態を反映)。
(B)赤いコロニーを継代すると、ほとんどのコロニーが赤くなる。一方、白いコロニーを継代するとほとんどのコロニーが白くなる。このことから、細胞は自身の遺伝子発現パターン(ヘテロクロマチン、ユークロマチンの状態)を記憶し、娘細胞へと継承することが分かった。
私たちは、ade6のヘテロクロマチン状態を示す赤いコロニー(ade6 OFF)が記憶できず、コロニーが白くなってしまう(ade6 ON)変異体を分裂酵母の遺伝子破壊株ライブラリー約3,400株の中から探索し、57個の変異体を同定することに成功しました。これら57個の遺伝子は、ヒストン修飾、DNA複製、RNA転写、核内構造、タンパク質の翻訳・翻訳後修飾・分解などに関わる因子をコードしていました。この結果は、遺伝子発現の細胞記憶に、多岐にわたる核内制御プロセスが関与していることを意味しています。重要なことに、分裂酵母で発見されたこれらの原因遺伝子の多くは、ヒトにも存在する遺伝子でした。
これらの因子の中で、今回私たちはMrc1に着目しました。Mrc1はDNA複製の際に、DNA情報の正確な複製を監視するタンパク質です (参考文献2)。mrc1遺伝子を欠損させると、赤いコロニーが維持できず、白いコロニーになることが分かりました (図2A)。この時、染色体上ではヒストンH3K14のアセチル化の程度が上昇し、H3K9のメチル化の程度が低下することが分かりました (図2A)。mrc1変異体では、ヘテロクロマチン構造が保たれずユークロマチン化し、RNA polymerase IIによる転写が活性化することが分かりました(図2A)。
さらなる解析の結果、Mrc1がH3K14のヒストン脱アセチル化酵素Clr3を含む複合体を呼び込むことで、H3K14の脱アセチル化状態を促進することが分かりました(図2B)。細胞記憶を維持するためには、DNA複製の際、細胞はDNAのみならず、それを取り巻くエピジェネティックな環境も正確に複製する必要があります。Mrc1はDNA複製の際に、DNAの正常な複製を監視しつつ、DNA周辺のエピジェネティックな状態の継承にも貢献していたのです (図2B)。

図2:Mrc1はヘテロクロマチンの安定な維持・継承を促進する Kawakami et al., 2024 Genes to Cells Fig.3より改変の後、転載 (1)。
(A)野生体(上図)では、赤いコロニーが安定に継代される。この際、ade6遺伝子の周辺の染色体では ヒストンH3K14のアセチル基がClr3により脱アセチル化され、Clr4によりH3K9のメチル化が起こり、RNA polymerase IIによる転写が抑制される。mrc1変異体(下図)では、赤いコロニーが維持できず、白いコロニーに変化する。この際、Clr3が呼び込まれず、H3K14のアセチル化の程度が上昇し、H3K9meの程度も低下する。その結果、RNA polymerase IIによる転写が起こる。
(B)Mrc1はDNA複製フォーク上で機能し、DNAの正常な複製を監視しつつ、H3K14の脱アセチル化を介して、ヘテロクロマチンの安定な維持・継承を促進する。
実は、Mrc1はDNAの複製の進行状態を監視する仲介因子(Mediator of DNA replication checkpoint)として、2001年に私たち自身が発見・命名した遺伝子でした (参考文献2)。それから20年以上の歳月が経った今、ヘテロクロマチン構造を親から娘細胞へと受け渡す、細胞記憶の仲介因子(Mediator of repressive chromatin state) として、再会を果たしました。酵母を用いた実験系の強みを活かした、先入観のない遺伝学的アプローチによって、1つの遺伝子について異なる生命現象への関連を示すに至りました。
【論文情報】
<著者>
Kei Kawakami*, Yukari Ueno1, Nao Hayama1, and Katsunori Tanaka*
* 責任著者
<論文タイトル>
Mrc1Claspin is essential for heterochromatin maintenance in Schizosaccharomyces pombe
<掲載ジャーナル>
Genes to Cells
<DOI>
https://doi.org/10.1111/gtc.13175
【特記事項】
本研究は、科学研究費補助金基盤研究(B)(代表:田中克典、分担:川上)、科学研究費補助金基盤研究(C)(代表:川上)、公益財団法人木下記念事業団(代表:川上)の支援を受けて、関西学院大学と島根大学との共同研究として行われました。
【参考文献】
1. Kawakami K, Ueno Y, Hayama N, Tanaka K. Mrc1(Claspin) is essential for heterochromatin maintenance in Schizosaccharomyces pombe. Genes Cells. 2024.
2. Tanaka K, Russell P. Mrc1 channels the DNA replication arrest signal to checkpoint kinase Cds1. Nature Cell Biology. 2001;3(11):966-72.
◎本研究の詳細(プレスリリース記事)についてはこちら
◆本件の連絡先
医学部総務課企画調査係
TEL:0853-20-2019・2531
Mail:mga-koho@office.shimane-u.ac.jp